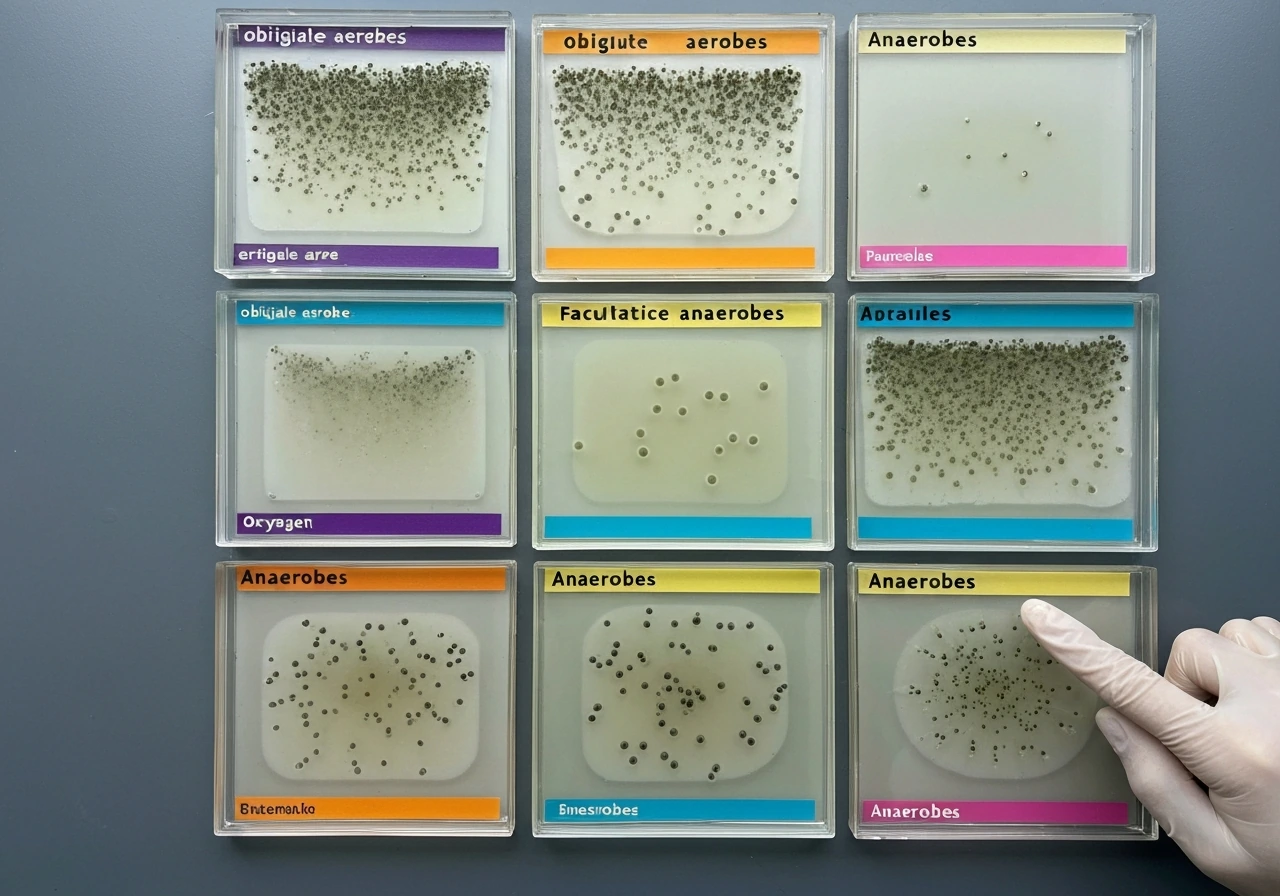
Oxygen-requirement categories showing different bacterial growth patterns

Bacteria that require oxygen to grow are called aerobic bacteria, and more specifically, those that cannot survive without it are called <a data-article-id="7606CCAB-0DA8-4B99-86A1-EF1DE1FC651F">obligate aerobes</a> (sometimes written as obligate aerobic bacteria or strict aerobes). That is the short answer. But if you are studying microbiology and trying to map this term to a broader classification scheme, there is a bit more to it, and understanding the full picture actually makes the concept stick much better.
Bacteria That Require Oxygen to Grow Are Called Aerobic
Aerobic bacteria vs. obligate aerobes: what the terms really mean
The word aerobic simply means oxygen-using. So any bacterium that uses oxygen as part of its metabolism qualifies as aerobic. The term obligate aerobe, though, is more specific: it describes bacteria that cannot grow without an abundant supply of oxygen. Take the oxygen away and they stop growing or die. Take the oxygen away and they stop growing or die. Obligate means required, non-negotiable, no alternatives. an organism that may even grow in certain chemical disinfectants is
The distinction matters because some bacteria are aerobic when oxygen is present but can survive without it by switching to a different energy strategy. Those that can grow with or without oxygen present are typically called facultative anaerobes, because they can switch their energy strategy organisms that can grow with or without oxygen present are. Those are not obligate aerobes. Calling every oxygen-using bacterium an obligate aerobe would be like calling everyone who drives to work a person who cannot walk. The terminology in microbiology is precise on this, and your textbook or exam question is almost certainly testing that precision.
The full oxygen-requirement classification scheme
Microbiology textbooks, including OpenStax, group bacteria into five categories based on how they respond to oxygen. Knowing all five helps you understand where obligate aerobes sit on the spectrum.
| Category | Relationship to Oxygen | Uses O2 as Electron Acceptor? | Classic Example |
|---|---|---|---|
| Obligate aerobe | Must have oxygen to grow | Yes, always | Pseudomonas aeruginosa |
| Facultative anaerobe | Prefers oxygen but can grow without it | Yes, when available | Escherichia coli |
| Obligate anaerobe (strict) | Cannot tolerate oxygen; grows only without it | Never | Clostridium botulinum |
| Aerotolerant anaerobe | Grows with or without oxygen but never uses it | Never | Enterococcus faecalis |
| Microaerophile | Requires oxygen but only at low concentrations | Yes, at reduced levels | Campylobacter jejuni |
Facultative anaerobes often come up alongside obligate aerobes because both use oxygen, which can cause confusion. The key difference: a facultative anaerobe can switch strategies when oxygen disappears. An obligate aerobe cannot. If you want to dig deeper into organisms that grow with or without oxygen, that classification (facultative) is a separate topic worth exploring on its own. Facultative anaerobes grow throughout the tube, and microaerophiles tend to congregate just below the surface in the reduced-oxygen zone. Many formulations include a color-indicator dye like resazurin, which changes color depending on the oxygen level at different depths, making the gradient visible. organisms which do not require oxygen to grow and survive
Why oxygen matters for bacterial growth in the first place
To understand why some bacteria need oxygen and others do not, you have to look briefly at how bacteria make energy. Like our own cells, bacteria need ATP (adenosine triphosphate), the cellular currency of energy. In aerobic bacteria, ATP is produced primarily through a process called oxidative phosphorylation, which depends entirely on an electron transport chain running along the bacterium's inner membrane.
Here is the key part: at the very end of that electron transport chain, electrons are handed off to a final acceptor. In aerobic respiration, molecular oxygen (O2) is that final acceptor. The reaction happens at the cytochrome oxidase level, where reduced cytochrome c reacts with O2 to complete the chain and drive ATP synthesis. No oxygen means the chain cannot complete, the process stalls, and the bacterium cannot generate enough energy to grow and reproduce. microorganisms that grow best in the absence of oxygen This includes organisms which require oxygen to grow and survive, since oxygen is their final electron acceptor.
Anaerobic bacteria have evolved to use other final electron acceptors, like sulfate, nitrate, or carbon dioxide, which is why they do not need oxygen. Obligate aerobes have not made that evolutionary trade-off. Their entire energy machinery is built around oxygen, so removing it is not just inconvenient, it is fatal.
How oxygen requirements are identified and verified in the lab

If you are learning about this in a lab setting or trying to understand how researchers actually confirm an organism's oxygen classification, there are a few standard approaches used in microbiology education and clinical labs.
Thioglycollate broth: the classic oxygen test
Thioglycollate broth is one of the most widely used tools for determining oxygen requirements. The broth creates a natural oxygen gradient: more oxygen near the surface where it diffuses in, less oxygen toward the bottom. When you inoculate a bacterial culture into this broth and incubate it, where the bacteria grow tells you a lot. Obligate aerobes cluster near the top where oxygen is highest. Obligate anaerobes grow only near the bottom. Facultative anaerobes grow throughout the tube, and microaerophiles tend to congregate just below the surface in the reduced-oxygen zone. Many formulations include a color-indicator dye like resazurin, which changes color depending on the oxygen level at different depths, making the gradient visible.
Incubation atmospheres and what terms to know

In a teaching lab, plates or cultures are often incubated under different atmospheric conditions to confirm growth patterns. The three most common setups you will encounter are ambient air (about 21% oxygen, standard aerobic conditions), a candle jar (slightly reduced oxygen, useful for microaerophiles), and a GasPak anaerobic jar (which removes oxygen almost entirely for growing strict anaerobes). An obligate aerobe will grow on plates incubated in ambient air and will fail to grow in the anaerobic jar. That contrast is often the clearest classroom demonstration of the concept.
When reading lab reports or textbook descriptions, you will also see terms like aerobic culture, anaerobic culture, and facultative growth used to describe how organisms are cultivated. These terms map directly back to the classification table above, so learning the vocabulary is half the battle.
Common examples and where you find obligate aerobes in the real world
Pseudomonas aeruginosa is one of the most frequently cited obligate aerobes in microbiology education, and it is a good example because it shows up in so many real-world contexts. It thrives in moist, oxygenated environments like soil, water, and the surfaces of medical devices. It is an opportunistic pathogen, meaning it can cause serious infections in people with compromised immune systems, burn victims, and patients on ventilators, precisely because those environments tend to be oxygenated and Pseudomonas is exceptionally good at exploiting them.
Other well-known obligate aerobes include Mycobacterium tuberculosis, the bacterium responsible for tuberculosis. It has a strong preference for high-oxygen tissues, which is why TB infections most commonly affect the upper lobes of the lungs, where oxygen levels are highest. That is not a coincidence; it is the bacterium's oxygen requirement expressing itself in infection ecology.
On the environmental side, Bacillus and Nocardia species include obligate or near-obligate aerobes commonly found in well-aerated soils. They play important roles in decomposition and nutrient cycling, and their presence in a soil sample can even serve as an indirect indicator of oxygen availability in that environment.
Real-world implications: food safety, hygiene, and growth conditions
Oxygen and food spoilage

Understanding oxygen requirements has very direct food safety applications. FAO guidelines for meat processing make this explicit: aerobic bacteria, because they have an absolute requirement for oxygen, are mostly limited to the surface of fresh meat where oxygen is available. This is why meat turns brownish-gray from the outside in, and why surface spoilage happens before deeper spoilage under aerobic conditions.
Vacuum packaging flips this equation. By removing oxygen, you suppress aerobic and obligate aerobic spoilage organisms, which extends shelf life. However, this creates a different risk: anaerobic bacteria, including Clostridium botulinum, the organism responsible for botulism, can thrive in low-oxygen environments. As the National Academies have noted, vacuum-packed products might look and smell perfectly fine (because aerobic spoilage organisms are suppressed) while actually harboring dangerous anaerobic pathogens. The food appears acceptable but may not be safe, which is one of the more important food safety lessons built around oxygen requirements.
Infection ecology and clinical environments
Oxygen gradients also shape infection dynamics inside the human body. When aerobic or facultative bacteria establish an infection in tissue, their own metabolic activity consumes oxygen. Over time, this depletes local oxygen levels and creates a microenvironment that is increasingly hospitable to anaerobic bacteria. In other words, early aerobic colonizers can pave the way for anaerobes, which is part of why complex infections often involve mixed bacterial communities. Knowing an organism's oxygen classification helps clinicians predict which bacteria might be involved and how infections might progress.
Hygiene and controlling growth conditions
From a hygiene perspective, oxygen control is one of the levers you can pull to either encourage or discourage microbial growth. Many common foodborne pathogens are aerobic, which means food storage practices that limit oxygen exposure can reduce their growth. Covering surfaces, sealing containers, and using modified atmosphere packaging all exploit the oxygen requirement of aerobic bacteria. At the same time, those practices require awareness of anaerobic risks, as discussed above. Oxygen is just one of several interconnected conditions (alongside temperature, pH, moisture, and available nutrients) that determine whether bacteria will thrive or stay dormant, and changing one condition often shifts the balance among different microbial populations.
Putting it all together
Bacteria that require oxygen to grow are called aerobic bacteria, and when the oxygen requirement is absolute, the precise term is obligate aerobe. The classification scheme that places them alongside facultative anaerobes, obligate anaerobes, aerotolerant anaerobes, and microaerophiles is the standard framework in microbiology, and the differences between these categories come down to how each organism handles the electron transport chain at the cellular level. In the lab, thioglycollate broth and controlled incubation atmospheres are the go-to tools for sorting organisms into these groups. In the real world, this classification matters everywhere from food packaging decisions to infection treatment to basic hygiene practices. Once you see oxygen requirements as a biological principle rather than just a vocabulary term, it connects to almost every other concept in microbial growth.
FAQ
What term should I use if a bacterium grows only when oxygen is present but tolerates very low oxygen?
If it can grow only when oxygen is available, but prefers higher levels (often described as “near-obligate” or “strictly oxygen-dependent”), many courses still label it as obligate aerobe based on practical growth failure in anaerobic conditions. If it shows reduced growth only under low-oxygen atmospheres, the classification might shift toward microaerophile or facultative depending on the specific growth pattern in controlled oxygen gradients.
Is “aerobic bacteria” the same as “obligate aerobes”?
No. “Aerobic bacteria” can mean any oxygen-using organism, including facultative aerobes and microaerophiles. “Obligate aerobes” are the subset that cannot grow without oxygen, so they fail in true anaerobic conditions.
Why do some textbooks include “obligate aerobe” and “strict aerobe” as alternatives?
They are commonly treated as equivalent in microbiology teaching, referring to the same core idea: growth requires oxygen. The “strict” wording is used to emphasize there is no workable fallback metabolism when oxygen is removed, unlike facultative organisms.
Can an obligate aerobe survive without oxygen for a while even if it cannot grow?
Yes. Many obligate aerobes may remain viable but non-growing during oxygen deprivation, especially for short periods, depending on stress resistance and inoculum size. The key exam distinction is that they do not proliferate (and often die over time) under oxygen-free conditions.
How do I tell facultative anaerobes apart from obligate aerobes in the lab?
Use an oxygen-gradient method or paired atmospheres. Facultative anaerobes typically grow both with oxygen and without it (often with differences in where growth is strongest), while obligate aerobes show growth only under oxygenated conditions and no growth in anaerobic setups.
What are common mistakes when using thioglycollate broth to classify oxygen requirements?
One mistake is over-interpreting faint growth. Another is incubating too long, since some organisms can show delayed effects or residual viability. Best practice is to read results at the standard time point used in your protocol and compare growth to control organisms with known oxygen requirements.
Why might an obligate aerobe still grow in a “supposedly anaerobic” jar?
Anaerobic jars can fail if oxygen is not adequately removed, if seals are compromised, or if the inoculum introduces oxygen-rich liquid. Also, very small oxygen traces can support growth for some organisms, so strict anaerobes are the more sensitive test, and jar performance should be verified with an oxygen indicator or protocol-specific controls.
Do oxygen requirements affect antibiotic treatment choices?
Often indirectly. Many antibiotics target processes tied to active metabolism, so if oxygen presence changes growth rate and energy generation, susceptibility can shift. Clinically, labs may infer oxygen-dependent physiology to help interpret culture results and choose treatments, but you generally should not select antibiotics solely based on oxygen classification.
In food safety, is “vacuum packaging is safe” a safe assumption for aerobic spoilage?
No. Removing oxygen suppresses aerobic spoilage and can extend shelf life, but it can also enable anaerobic pathogens and toxin production (for example, certain Clostridium species). Storage conditions, packaging integrity, and processing steps still determine safety, even if the product looks or smells acceptable.
How does mixed infection relate to oxygen requirements?
Oxygen-demanding bacteria can consume oxygen early, creating conditions where oxygen is lower and anaerobes become more competitive later. This is why clinicians often see polymicrobial infections, and why the oxygen profile of the site can influence which organisms dominate over time.




